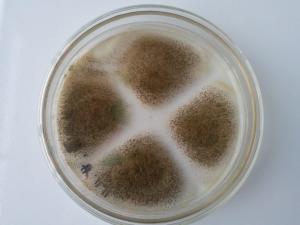

- 曲霉属

曲霉属
简介
Aspergillus
分生孢子梗由一根直立的菌丝形成,菌丝的末端形成球状膨胀(顶囊),在一些种中,顶囊部分的或全部的为瓶梗(初生小梗)融合层所覆盖,而在大部分种中,顶囊由小梗(初生小梗或梗茎)融合层和瓶梗的融合重叠层所覆盖。每个瓶梗向茎地产生一条球形、有色、不分隔的分生孢子链。根据种的不同,分生孢子可以是黄色、绿色或黑色等。
分布种类
曲霉属(6)此属在自然界分布极广,是引起多种物质霉腐的主要微生物之一(如面包腐败、煤生物分解及皮革变质等)。其中以黄曲霉具有很强毒性。绿色和黑色的具有很强的酶活性,在食品发酵中广泛用于制酱、酿酒。现代发酵工业中用于生产葡萄糖氧化酶、糖化酶和蛋白酶等酶制剂。其他菌株有:黄曲霉(A. flavus),烟曲霉(A. fumigatus),灰绿曲霉(A. glaucus),构巢曲霉(A. nidurans),寄生曲霉(A. parasiticus),土曲霉(A. terreus)和杂色曲霉(A. versicolor)等。
曲霉属(6)此属在自然界分布极广,是引起多种物质霉腐的主要微生物之一(如面包腐败、煤生物分解及皮革变质等)。其中以黄曲霉具有很强毒性。绿色和黑色的具有很强的酶活性,在食品发酵中广泛用于制酱、酿酒。现代发酵工业中用于生产葡萄糖氧化酶、糖化酶和蛋白酶等酶制剂。其他菌株有:黄曲霉(A. flavus),烟曲霉(A. fumigatus),灰绿曲霉(A. glaucus),构巢曲霉(A. nidurans),寄生曲霉(A. parasiticus),土曲霉(A. terreus)和杂色曲霉(A. versicolor)等。
特征
霉菌中的一群,包括米曲霉、黑曲霉等。一般是从匍匐于基质上的菌丝向空中伸出球形或椭圆形顶囊的分生孢子梗,在其顶端的小梗或进一步分枝的次级小梗上生出链状的分生孢子。在不具有性生殖的种类中虽少,但都产生封闭的子囊果。以米曲霉为主的霉菌,大都和酒、豆酱、酱油等的酿造有密切关系。一方面有很多菌种可被用于各种有益物质的生产,如用于蛋白消化剂的蛋白酶(酱油曲霉)、柠檬酸(黑曲霉)、衣康酸(土曲霉、解乌头酸曲霉)以及曲酸(黄曲霉)等。但另一方面,也有不少侵害家禽、家畜甚至人体内脏特别是呼吸器官的病菌,如引起曲霉症的烟曲霉,以及产生剧毒的黄曲霉毒素的A.sPer-gillus Parasiticus var.globosus等。此外,黑曲霉常被用作实验材料。在蚕硬化病中,有一种曲霉病,是幼蚕期的重要蚕病,其病原菌即是黄曲霉(褐僵病菌)、米曲霉(曲病菌)等霉菌。

-
厦门火炬特种金属材料有限公司
2025-09-29 04:24:13 查看详情


 求购
求购









